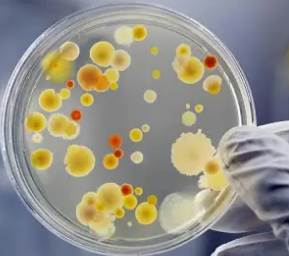
BioHazard fee - Nature Maid Total Home Services

1
/
of
1
Nature Maid Total Home Services
BioHazard fee
BioHazard fee
This fee applies to any occurence of rodents, insects such as cockroaches, (bed bugs will be automatically rejected), feces, urine, either animal or human excrement. Each occurence will incur its own fee. A dead rodent is one occurence, insects in the same home/office is another occurence. This not only presents a danger to our staff, but also presents a danger to our equipment and supplies. It requires us to fumigate and also dispose of items.
Share
Couldn't load pickup availability